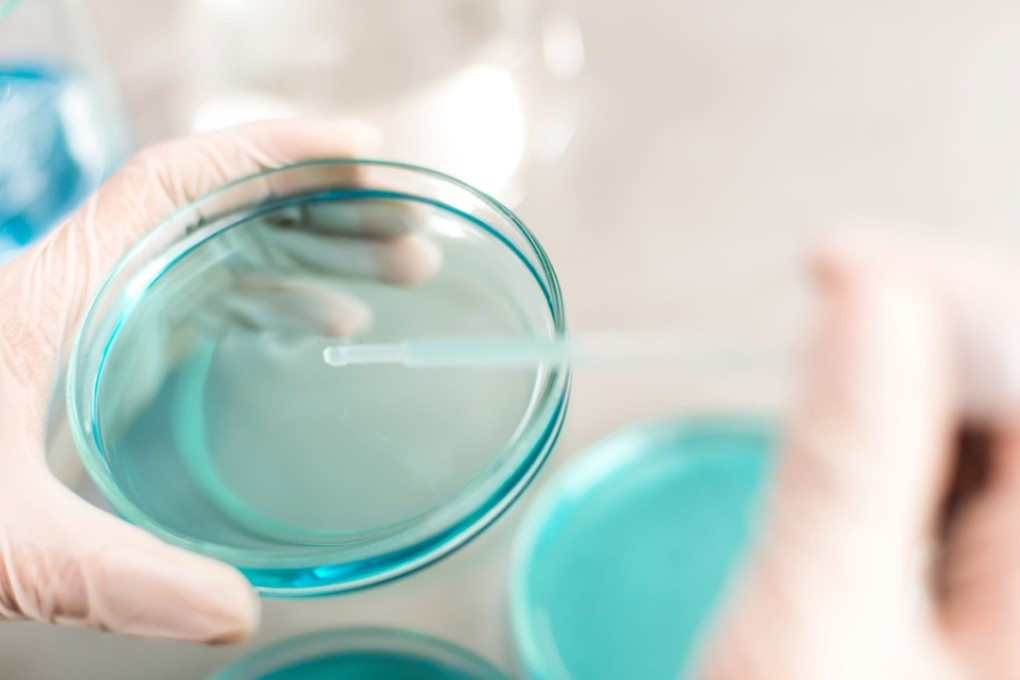
GenScript’s shares fell sharply in the wake of report by Flaming Research in late September. Photo: Shutterstock

Short sellers are taking aim at Hong Kong’s emerging tech industries
A short-seller attack on a Chinese biotech company has highlighted the growing risks for investors in new economy companies in Hong Kong, analysts say.
The Hong Kong shares of GenScript Biotech Corp fell sharply on September 27 in the wake of a report by Flaming Research which alleged that the New Jersey-based company had fabricated clinical data.
The report, the first of two released by Flaming Research on the company, underscores how short sellers have shifted tactics, taking closer aim at new economy stocks just as the city is making a push to attract companies ranging from biotech to fintech.
In a similar incident, shares of Chinese online lender Chong Sing Holdings Fintech Group slumped in September after Bonitas Research questioned its financial reporting. Both companies targeted by the short sellers have denied the allegations.
“There is an increasing tendency for short sellers to target new economy companies because their business is not as tangible,” said Kevin Leung, executive director of investment strategy at Haitong International Securities. “How prepared are investors for such attacks? I’d say not so much.”
These companies, though poised for potentially high growth, have yet to demonstrate a track record of profitable operation, while their underlying technology has yet to BE successfully commercialised, factors that can make it difficult for investors to discern whether the short-sellers are putting forward a legitimate case, analysts say.